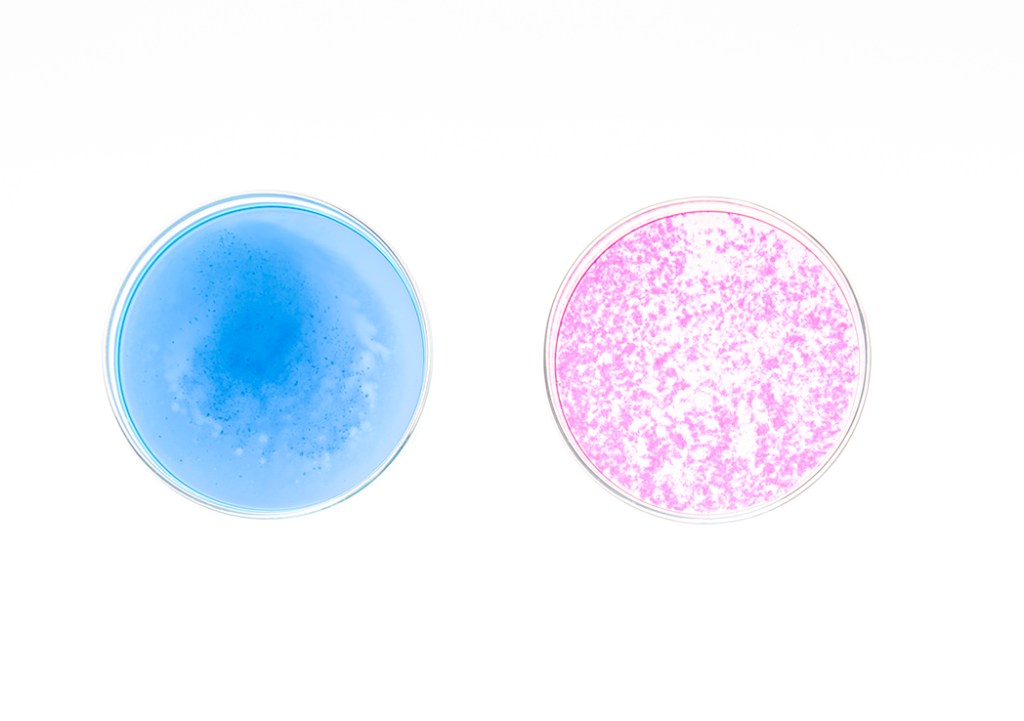

Schwerpunkt der Arbeiten am IMD Institute for Materialdesign and Advanced Material Studies ist die Rolle des Materials im Gestaltungsprozess. Aus materialgerechtem Gestalten wird ein „Gestalten mit gestalteten Materialien“.
The focus of the work at the IMD Institute for Materialdesign and Advanced Material Studies IMD is the role of the material in the design process. Material-appropriate design becomes „design with designed materials“

Insect Embassy – Eine diplomatische Vertretung für Insekten in der Stadt
Übergroß aufgespannt an einem Stadtbaum finden Sie hier eine Struktur vor, die an die Bau- und Lebensweise von Insekten erinnert. Die Insect Embassy fordert uns Menschen dazu auf, nachzudenken, in welchen konstruktiven oder destruktiven Beziehungen jede*r Einzelne von uns mit Insekten steht. Sie ist ein Appell, die diplomatischen Beziehungen zwischen Menschen und Insekten wiederaufzunehmen.
Oversized and suspended from a city tree, you can observe a structure referencing the construction and life forms of insects. The Insect Embassy challenges us to stop and think about our own constructive and destructive relations to insects. It is a call to take up the diplomatic relations between humans and insects.
In Kooperation mit / In cooperation with: Institut für sozial-ökologische Forschung
Teilnehmer_innen / Participants:
Alexander Becker, Marius Perl, Tobias Doch, Kamola Khudayberdieva, Markus Löffelholz, Antoine Ochs, Julia Schütze, David Wellen, Tobias Walter, Florim Fteja, Ani Jishkariani
Projektbetreuung /Supervision:
Dipl. Des. Valentin Brück, Dr. Ziyu Zhou, M. Sc. Ludwig Ebert
Projektleiter / Project leaders:
Prof. Dr. Markus Holzbach
Dr. Florian Dirk Schneider
The Insect Embassy is a collaboration between the IMD and the ISOE – Institute for Social-Ecological Research. The Insect Embassy was created as part of the research project „SLInBio – Urban Lifestyles and the Valorization of Biodiversity,“ which is funded by the German Federal Ministry of Education and Research (BMBF) as part of the BMBF research initiative for the preservation of biodiversity (FEdA)
IMD Institut für Materialdesign an der Hochschule für Gestaltung hfg Offenbach am Main
IMD Institute für Materialdesign at the University of art and design hfg Offenbach am Main





MA – Between Nature and Craftmanship
“MA – Between Nature and Craftsmanship” is a collaborative design work between the Institute for Materialdesign IMD at the Offenbach University of Art and Design, and Mazda Motor Corporation. The team of IMD used the material design approach to understand, interpret, and explore Japanese craftsmanship in different fields and historical periods, and then integrated these innovative hands-on experimentation results generated in the new context into the concept of the project. Inside the structure, sensor controlled light sources let the object interact with its surroundings.
In Kooperation mit / In cooperation with: Mazda Europe
Teilnehmer_innen / Participants: Sophie Bernauer, Mi Düver, Julia Kulaga, Lennard Ludig,
Dipl. -Des. Florian Hundt
Projektbetreuung /Supervision:
Prof. Dr. Markus Holzbach, Dipl.-Des. Valentin Brück, Dr. Ziyu Zhou (IMD Institut für Materialdesign)
Jo Stenuit (Mazda Europe), Sandra Hoener zu Bentrup (Mazda Europe),
Fotos: Bernd Schuster (Mazda)
IMD Institut für Materialdesign an der Hochschule für Gestaltung hfg Offenbach am Main
IMD Institute für Materialdesign at the University of art and design hfg Offenbach am Main







imd_plant transistor- Talking Plants
Anlässlich des 150-jährigen Palmengartenjubiläums haben sich Gestalter_innen und Künstler_innen mit dem Palmengarten und seinen „Transformationen“ im Wandel der Zeit auseinandergesetzt.
Studierende des Instituts für Materialdesign IMD der Hochschule für Gestaltung in Offenbach gestalteten hierfür einen Pavillon, der die Bedeutung des Palmengartens als Begegnungsort zwischen Pflanze, Natur und Mensch beinhaltet. Dabei steht vor allem der symbiotische Dialog von Natur und Kultur im Fokus.
On the occasion of the 150th anniversary of the Palmengarten, designers and artists have dealt with the Palmengarten and its „transformations“ over the change of time.
Students from the Institute for Materialdesign IMD at the Hochschule für Gestaltung in Offenbach designed a pavilion, which includes the importance of the palm garden as an encounter place among plants, nature, and people. The main focus is on the symbiotic dialogue between nature and culture.
In Kooperation mit / In cooperation with: Palmengarten Frankfurt
Teilnehmer_innen / Participants: Lisa Bartz, Kira Bernauer, Sophie Bernauer, Johannes Bietz, Till Eser, Lucas Glittenberg, Noa Haller, Nina Jäcker, Lennard Ludig, Zachary Mentzos, Leonard Neunzerling, Josephine Pavesi, Daniel Wolff
Besonderer Dank/Special thanks: Palmengarten Team, Stephan Blanché, Michael Langsdorf, Adrian Kitzinger, Robert Langer, Ziyu Zhou
Projektbetreuung /Supervision:
Prof. Dr. Markus Holzbach, Dipl.-Des. Valentin Brück
Video: https://vimeo.com/755183890
IMD Institut für Materialdesign an der Hochschule für Gestaltung hfg Offenbach am Main
IMD Institute für Materialdesign at the University of art and design hfg Offenbach am Main







Keramikdruck
Durch die experimentelle Auseinandersetzung mit Materialien und Halbzeugen, die über eine identische oder ähnliche Gestalt verfügen, sollen formbestimmende Strukturen generiert oder gefunden werden. Der Fokus liegt auf dem Einsatz des 3D-Keramikdruckers. Zentrale Aspekte sind dabei der entwerferische Gestaltungswille, die formbestimmende Logik des Materials und/oder die Chancen und Restriktionen der eingesetzten Formgebungsverfahren.
Form-defining structures are to be generated or found through the experimental examination of materials and semi-finished products that have identical or similar shapes. It stresses the use of the 3D ceramic printer with the creative will, the form-determining logic of the material and/or the opportunities and restrictions of the shaping processes used as central aspects.
Teilnehmer_innen / Participants: Christian Struwe, Christina Timmann, Jun Jin, Philip Kleine, Homa Soleimani, Johann Rambow, Lukas Loscher, Isenia Spatola, Celina Almendarez, Kira Bernauer, Nika, Gavran, Jonas Nitsch, Noa Haller, Marlene Bruch, Julia Huber, Yujin Kang
Projektbetreuung / Supervision:
Prof. Dr.-Ing. Arch. Markus Holzbach, Dipl.-Des. Valentin Brück, Dipl.-Des. Lennard Wilde
IMD Institut für Materialdesign an der Hochschule für Gestaltung hfg Offenbach am Main
IMD Institute für Materialdesign at the University of art and design hfg Offenbach am Main





Sneature
Sneature ist der Entwurf eines abfallbasierten Turnschuhs. Upgecycelte Roh- und Abfallstoffe wurden für die Entwicklung eines biologischen Materialkreislaufes untersucht. Die Verwendung von additiven Fertigungsmethoden, wie 3D-Druck oder 3D-Stricken, ermöglicht sowohl eine individuelle Anpassung an den Nutzer als auch eine On-Demand-Produktion bei minimalem Energieaufwand.
Sneature is a sneaker design based on waste. Upcycled raw and waste materials were examined for the development of a biological material cycle. The use of additive manufacturing methods such as 3D printing or 3D knitting enables both customizations to the user and on-demand production with minimal energy consumption.
Kooperationspartner / Cooperation-partner: Modus Intarsia
Diplomarbeit von / Diplom project by Emilie Burfeind
Projektbetreuung / Supervision: Prof. Dr. Markus Holzbach, Dipl. Des. Valentin Brück
IMD Institut für Materialdesign an der Hochschule für Gestaltung hfg Offenbach am Main
IMD Institute für Materialdesign at the University of art and design hfg Offenbach am Main





Eco-Morphia
Die Installation „ECO_MORPHIA“ stellt einen symbiotischen Dialog von Natur und Kultur dar. Häufig versucht in solchen Natur-Kultur-Korrelationen eines der Systeme ein anderes zu übernehmen und erfahrungsgemäß dominiert dabei die Kultur nur allzu häufig die Natur. Die eigentliche Faszination liegt auf dem scheinbar unerschöpflichen Adaptionsvermögen der Natur und der Interaktion der belebten Natur mit der vom Menschen gestalteten Umwelt.
The installation „ECO_MORPHIA“ represents a symbiotic dialogue between nature and culture. In such nature-culture correlations, one of the systems often tries to take over another, and experience has shown that culture all too often dominates nature. The real fascination lies in nature’s apparently inexhaustible adaption ability and the interaction of living nature with the human-designed environment.
In Kooperation mit / In cooperation with: Palmengarten Frankfurt, Btv-Furniere GmbH
Teilnehmer_innen: / Participants Lara Bohe, Delphine Collet, Marius Dittmar, Seyed Arash Mousavi Gharavi, Philip Landgrebe, Lucas Glittenberg, Andreas Grimm, Catharina Köhler, Dylan McGuire, Leonie Morbach, Cornelia Stehling
Projektbetreuung / Supervision: Prof. Dr. Markus Holzbach, Dipl.-Ing Tatjana Gorbachewskaja
IMD Institut für Materialdesign an der Hochschule für Gestaltung hfg Offenbach am Main
IMD Institute für Materialdesign at the University of art and design hfg Offenbach am Main


Fractal Chaos
Die Arbeit ‚Fractal Chaos’ setzt sich mit der Wiederholbarkeit des Unvorhersehbaren auseinander. Ziel war es, die Formgestaltung durch einen nicht artifiziell geplanten, konzeptualisierten, klassischen Designprozess zu generieren, sondern durch natürliche Krafteinwirkung. Im erhitzten, somit flüssigen Zustand, wurde das Material aus verschiedenen Höhen in verschiedenen Flüssigkeiten implementiert. Die Formvarianz entstand durch Varianz in der Oberflächenspannung der einzelnen Versuchsaufbauten. Die Wiederholbarkeit konnte eindeutig in den Versuchen bestätigt werden.
Zur Visualisierung wurde der Prozess automatisiert. Dazu wurde ein Auffangbecken generiert, welches sich formelästhetisch natürlichen Gewässern annähert und durch konzentrische Beckenunterteilung das Topfen des Materials rezitiert.
The work ‚Fractal Chaos‘ deals with the repeatability of the unpredictable. The goal was not to generate the shape through a not artificially planned, conceptualized, classic design process, but through natural forces. The material was implemented from different heights in different liquids in the heated state. The shape variance was caused by the surface tension variance of the individual test setups. The repeatability was clearly confirmed in the tests. The process was automated for visualization. For this purpose, a catch basin was generated, which aesthetically approximates natural water bodies and recites the potting of the material through concentric basin subdivisions.
Projekt von / Project by Lara Bohe
Projektbetreuung / Supervision: Prof. Dr. Markus Holzbach
IMD Institut für Materialdesign an der Hochschule für Gestaltung hfg Offenbach am Main
IMD Institute für Materialdesign at the University of art and design hfg Offenbach am Main



digital nature
Die Verschneidung von Natur und Technologie nimmt immer mehr zu. Es werden nicht nur bionische Prinzipien aus der Natur in technologische Prozesse abstrahiert, sondern auch zunehmend natürliche Materialien in Gestaltungsprozesse integriert.
The intersection of nature and technology is increasing. Not only are bionic principles from nature being abstracted into technological processes, but natural materials are also increasingly being integrated into design processes.
Projekt von / Project by Andreas Grimm
Projektbetreuung / Supervision: Prof. Dr. Markus Holzbach
IMD Institut für Materialdesign an der Hochschule für Gestaltung hfg Offenbach am Main
IMD Institute für Materialdesign at the University of art and design hfg Offenbach am Main





Maku
Maku ist ein 3D-gedrucktes, pneumatisches System. In einem speziell entwickelten Druckverfahren werden Mikroorganismen in einer Nährlösung in flüssiges Silikon gedruckt.
Das System agiert autonom und benötigt keine weiteren Hilfsmittel.
Maku is a 3D-printed pneumatic system. In a specially developed printing process, microorganisms are printed in liquid silicone in a nutrient solution. The system acts autonomously and requires no additional components.
Diplomprojekt von / Diplom project by Valentin Brück
Projektbetreuung / Supervision: Prof. Dr. Markus Holzbach, Dipl.-Des. Steffen Reiter
IMD Institut für Materialdesign an der Hochschule für Gestaltung hfg Offenbach am Main
IMD Institute für Materialdesign at the University of art and design hfg Offenbach am Main

Glas_Hybrids
Im Projekt „GLAS_hybrids” wurden in Zusammenarbeit mit dem IKKG der Hochschule Koblenz und den dortigen Glaswerkstätten konzeptionelle Materialstudien entwickelt.
Dem direkten Umgang mit unterschiedlichen Materialien und der von entsprechenden Versuchsreihen geprägten Auseinandersetzung wurde im Projekt „GLAS_hybrids” Raum gegeben.
Besonderer Dank gilt dem IKKK der Hochschule Koblenz und den dortigen Werkstätten. Thomas Kohl, Jesse Magee und Christian Schultz haben unsere Kooperation ermöglicht und wesentlich zum Gelingen des Semesterprojekts und der Einzelarbeiten beigetragen.
Space was given to the direct handling of different materials and the examination shaped by the corresponding test series in the project. Special thanks to the IKKK at the Koblenz University of Applied Sciences and the workshops there. Thomas Kohl, Jesse Magee and Christian Schultz made our cooperation possible and significantly contributed to the success of the semester project and the individual work.
Kursteilnehmer_innen / Participants: Amelie Ikas, Delphine Collet, Emilie Burfeind, Franca Tasch, Julia Huber, Michael Watene, Nathalie Thiel, Samira Kara, Sophia Kirwald, Stella Krause
Projektbetreuung / Supervision: Prof. Dr. Markus Holzbach, Thomas Kohl
IMD Institut für Materialdesign an der Hochschule für Gestaltung hfg Offenbach am Main
IMD Institute für Materialdesign at the University of art and design hfg Offenbach am Main







plant b
Das Projekt “plant b” beschäftigt sich mit alternativen Fertigungsmethoden in der Gestaltung vor dem Hintergrund biobasierter, zirkulärer Stoffkreisläufe. Aus biologisch abbaubaren Material bestehende Strukturen werden gedruckt und mit wachsenden Organismen versetzt.
The „plant b“ project deals with alternative production methods in design in the context of bio-based, circular material cycles. Structures made of biodegradable material are printed and inoculated with growing organisms.
Projekt von / Project by Andreas Grimm und Emilie Burfeind
Projektbetreuung / Supervision: Prof. Dr. Markus Holzbach, Dipl.-Des. Steffen Reiter
IMD Institut für Materialdesign an der Hochschule für Gestaltung hfg Offenbach am Main
IMD Institute für Materialdesign at the University of art and design hfg Offenbach am Main





Synthetische Mineral Akkretion
Das mit diesem Projekt aufgezeigte Verfahren beschäftigt sich mit gezielter Materialanlagerung durch einen materialinspirierten Prozess zur Herstellung von stahlarmierten mineralischen Strukturbauteilen.
The method shown in this project deals with the targeted accumulation of material through a material-inspired process for the production of steel-reinforced mineral structural components.
Projekt von / Project by Florian Hahn
Projektbetreuung / Supervision: Prof. Dr. Markus Holzbach
IMD Institut für Materialdesign an der Hochschule für Gestaltung hfg Offenbach am Main
IMD Institute für Materialdesign at the University of art and design hfg Offenbach am Main






Particel
Das Themenfeld Partikel eröffnet unter Einsatz analoger und digitaler Werkzeuge ein dynamisches Experimentierfeld für reale und digitale Formfindungsstrategien. Inspiriert durch die Natur, die sich durch Aufbau und Abbau von ‚Material’ in einem stetigen Erneuerungsprozess befindet, soll durch das Denken und Planen in dynamischen Materialisierungs- und/oder Entmaterialisierungsprozessen das Steuern von Partikeln in einem System umgesetzt werden, um somit Wege optimierter Formfindung und Selbstorganisation zu entwickeln. Es bietet sich an, das physische Modell mit einem virtuellen Modell zu koppeln, um sich die jeweiligen Vorteile bzw. Synergieeffekte zunutze zu machen.
The topic of particles opens up a dynamic field of experimentation for real and digital form-finding strategies using analogue and digital tools. Inspired by nature, which is in a constant process of renewal through the construction and degradation of ‚material‘, the control of particles in a system should be implemented through thinking and planning in dynamic materialization and/or dematerialization processes, in order to find ways of optimized form and develop self-organization. It makes sense to combine the physical and virtual models to take advantage of the respective advantages and synergy effects.
I Kooperation mit / In cooperation with Dr. Dorte Janussen, Senckenberg Forschungsinstitut und Naturmuseum Frankfurt am Main
Projektbetreuung / Supervision: Prof. Dr. Markus Holzbach, Dipl.-Des. Steffen Reiter, Dipl.-Des. Benjamin Würkner
IMD Institut für Materialdesign an der Hochschule für Gestaltung hfg Offenbach am Main
IMD Institute für Materialdesign at the University of art and design hfg Offenbach am Main


LEM-Intelligent Skin
Mobilität zwischen Digitalität und Exploration
Mobilität ist eine der zentralen Errungenschaften unserer zivilisierten Welt und stellt ein wesentliches Merkmal unserer modernen Gesellschaft dar. Im Zeitalter der Ressourcenknappheit werden neue Mobilitätskonzepte diskutiert. Einen wesentlichen Aspekt in diesen Überlegungen stellen die neueren Errungenschaften der Informationstechnologie dar. Zukünftige Mobilitätsformen werden über nie dagewesenes Potential an Konnektivitäten verfügen. Mit dem Projekt „LEM – intelligent skin“ kooperierten die designfabrik® der BASF mit Hyundai Europe und dem Institut für Materialdesign IMD an der HfG Offenbach bereits zum zweiten Mal.
Mobility between digitality and exploration
Mobility is one of the central achievements of our civilized world and represents an essential feature of our modern society. In the age of resource scarcity, new mobility concepts are being discussed. The more recent achievements in information technology represent an essential aspect of these considerations. Future forms of mobility will have unprecedented potential for connectivity. With the „LEM – intelligent skin“ project, BASF’s designfabrik® cooperated with Hyundai Europe and the Institute for Material Design IMD at the HfG Offenbach for the second time
In Kooperation mit / In cooperation with: BASF designfabrik®, Hyundai Europe
Teilnehmer_innen / Participants: Alex Huschka, Andreas Grimm, David Maurer, Emilie Burfeind, Florian Hundt, Isabel Kovacevic, Julia Huisken, Lennard Wilde, Lisa Chiera, Lukas Porstner, Markus Mau, Maurice Riegler, Ricardo Ponce, Valentin Brück, Valentin Maskow
Soundkonzept / Sound-concept: Matthias Ockert
Projektbetreuung / Supervision: Prof. Dr. Markus Holzbach, Dipl.-Des. Steffen Reiter, Dipl-Des. Benjamin Würkner
IMD Institut für Materialdesign an der Hochschule für Gestaltung hfg Offenbach am Main
IMD Institute für Materialdesign at the University of art and design hfg Offenbach am Main







Traumraum
Traumraum ist eine interaktive Rauminstallation nach Heiner Müllers Bildbeschreibung.
Es handelt sich um ein studentisches Kooperationsprojekt der beiden Fachbereiche Design und Kunst,
an der Hochschule für Gestaltung in Offenbach;
Bühnenbild (Prof. rosalie) und Materialdesign (Prof. Dr. Markus Holzbach).
Der Traumraum spielt mit den Materialeigenschaften von Textil und Paraffin in Hinsicht auf Festigkeit, der Tragfähigkeit des eigenen Gewichtes und unterschiedlichen optischen und
haptischen Oberflächenqualitäten. Als Interpretation der Bildbeschreibung von Heiner Müller, versteht sich die interaktive Licht- und Soundinstallation als Erlebniskonzept, welche den Besucher auf poetische
Weise die Materie als Raum erfahren lässt.
Traumraum is an interactive room installation based on Heiner Müller’s picture description. It is a student cooperation project between art and design departments at the Offenbach University of Art and Design;
Stage design (Prof. Rosalie) and Material design (Prof. Dr. Markus Holzbach). Traumraum plays with the material properties of textile and paraffin in terms of strength, and the carrying capacity of its own weight with different optical and haptic surface qualities. As an interpretation of Heiner Müller’s description of the image, the interactive light and sound installation create an experience concept that conveys to the visitor in a poetic way to experience matter as space.
Teilnehmer_innen / Participants:
Angelina Ambrosch, Viviane Niebling, Chengtian Luo, Valentin Maskow, Marthe Schliephacke, Ricarda Bechstein, Lucia Bushart, Valentin Brück, Veronica Trebini
Projektleitung/Project Lead:
Prof. rosalie, Prof. Dr. Markus Holzbach
Betreuung/Supervision:
Nina Zoller, Dipl.-Ing. Tatjana Gorbachewskaja, Dipl. Des. Benjamin Würkner, Dipl. Des. Lilian Dedio
IMD Institut für Materialdesign an der Hochschule für Gestaltung hfg Offenbach am Main
IMD Institute für Materialdesign at the University of art and design hfg Offenbach am Main





Riccio
Die experimentelle Raum- und Materialstudie Riccio entstand als Forschungsprojekt am IMD und demonstriert einen ‚materialorientierten‘ Gestaltungsansatz. Hierbei werden die Eigenschaften eines dreidimensionalen Textils (weich) mit denen einer keramischen Matrix (fest) kombiniert und mittels digitaler wie analoger Verarbeitungstechnologien zur Generierung von leichten keramischen Schalenbauteilen genutzt. Die Schalenformen beruhen auf der Möglichkeit, ein Textil mit eigener Flächenartikulation und gegensinnig gekrümmten Geometrien im Raum aufzuspannen. Riccio setzt sich aus sechs dünnwandigen Schalenelementen, gefertigt aus dem textilarmierten, keramischen Verbundwerkstoff, zusammen.
The experimental space and material study Riccio was created as a research project at the IMD and demonstrated a ‚material-oriented‘ design approach. The properties of a three-dimensional textile (soft) are combined with those of a ceramic matrix (firm) and used to generate lightweight ceramic shell components using digital and analogue processing technologies. The shell shapes are based on the possibility of stretching a textile with its own surface articulation and geometries curved in opposite directions in space. Riccio consists of six thin-walled shell elements made of the textile-reinforced, ceramic composite material.
Promotionsprojekt von/ PhD – Project by Nico Reinhardt
Projektbetreuung / Supervision: Prof. Dr. Markus Holzbach
IMD Institut für Materialdesign an der Hochschule für Gestaltung hfg Offenbach am Main
IMD Institute für Materialdesign at the University of art and design hfg Offenbach am Main



Engelstrompete
Pavillon im Palmengarten zur Luminale 2012 – Biennale der Lichtkultur Frankfurt am Main
Bei der Engelstrompete handelt es sich um eine nachhaltige und temporäre Rauminstallation. Die konstruktive Ausprägung des Raumes wird von einem leichten, blattähnlichen und modularen Flächentragwerk bestimmt. Sämtliche Materialien können problemlos getrennt werden, es werden keine umweltbelastenden Stoffgemische genutzt oder hergestellt. In seiner formalen Gestaltung bezieht sich die Umhüllung auf die Konstruktion der Blüte der Engelstrompete. Eine transluzente Membran aus Metallgewebe bildet die schillernde Haut zwischen den hölzernen Blattrippen und dient gleichzeitig als Reflexionsfläche für Lichtprojektionen.
Pavilion in the Palmengarten for Luminale 2012 – Biennale of Light Culture Frankfurt am Main Engelstrompete is a sustainable and temporary room installation. The constructive character of the room is determined by a light, sheet-like, and modular surface structure. All materials can be easily disassembled, and no environmentally harmful mixtures of substances are used or manufactured. In its formal design, the cover refers to the construction of the blossom of the angel’s trumpet. A translucent membrane made of metal fabric forms the shimmering skin between the wooden leaf ribs and at the same time serves as a reflection surface for light projections.
Projektteilbnehmer_Innen / Participants: Aldo Freund, Philip Kliem, Barbara Wildung, Benjamin Würkner
Projektleitung / Project Lead: Prof. Dr. Markus Holzbach
Sound: Dominik Eulberg
Fotos / Pjpotography : Emily Wabitsch
IMD Institut für Materialdesign an der Hochschule für Gestaltung hfg Offenbach am Main
IMD Institute für Materialdesign at the University of art and design hfg Offenbach am Main







Magnetic Fabrics
Integrierte, magnetische Komponenten versetzen die Materialstudie in Bewegung und erzeugen ein poetisches Eigenleben der textilen Flächen. In ihrer Bewegung veranschaulicht die Arbeit den Zusammenhang von Material und Form.
Integrated, magnetic components set the material study in motion and create a poetic life of its own in the textile surfaces. In its movement, the work illustrates the connection between material and form.
In Kooperation mit / In coopertion with: BMW AG
Projekt von / Project byLilian Dedio
Projektbetreuung / Supervision: Prof. Dr. Markus Holzbach
IMD Institut für Materialdesign an der Hochschule für Gestaltung hfg Offenbach am Main
IMD Institute für Materialdesign at the University of art and design hfg Offenbach am Main


Blunero
Normalerweise unterliegt eine Flüssigkeit ihren eigenen physikalischen Gesetzen. Blunero erschafft eine unerwartete und materialfremde Ästhetik über fremdbestimmte Bewegungsprofile.
Normally, a liquid is subject to its own physical laws. Blunero creates an unexpected aesthetic that is alien to the material and uses movement profiles determined by others.
Projekt von / Project by Luigi Galbusera
Projektbetreuung / Supervision: Prof. Dr. Markus Holzbach
IMD Institut für Materialdesign an der Hochschule für Gestaltung hfg Offenbach am Main
IMD Institute für Materialdesign at the University of art and design hfg Offenbach am Main



Paralightskin
Vibration, Berührung und Druck lassen das Material reagieren und erzeugen ein optisches Feedback. Paralightskin ist der Ansatz, das bestehende Bild einer automotiven Oberfläche zu überwinden, die Eigenschaft einer technischen Haut neu zu überdenken und seine Erscheinungsform neu zu interpretieren.
Vibration, touch and pressure make the material react and create visual feedback. Paralightskin is an approach to overcome the existing image of an automotive surface, rethinking the properties of a technical skin and reinterpreting its appearance.
In Kooperation mit / In cooperation with : Prof. Peter Eckart, Evonik Industries AG
Projekt von / Project by Martin Pohlmann, Julian Schwarze, Johannes Wöhrlin
Projektbetreuung / Supervision: Prof. Dr. Markus Holzbach
IMD Institut für Materialdesign an der Hochschule für Gestaltung hfg Offenbach am Main
IMD Institute für Materialdesign at the University of art and design hfg Offenbach am Main


Bits&Bytes
Allgegenwärtig begegnen uns quadratische Flächen und Fenster zu binären Inhalten. Damit bricht der vorliegende Entwurf. Die Technik eröffnet neue Gestaltungsspielräume im Bereich der Formgebung. Durch Headtracking können die digitalen Inhalte zudem auf die individuelle Perspektive des Nutzers abgestimmt werden und ermöglichen so eine virtuelle Tiefe des Materials.
We encounter square surfaces and windows to binary content everywhere. This design breaks with this. Technology opens up new scopes in the field of design. Head tracking can also be used to tailor the digital content to the user’s individual perspective, thus enabling a virtual depth of the material.
In Kooperation mit / In cooperation with: BMW AG
Projekt von / Project by Markus Mau
Projektbetreuung / Supervision: Prof. Dr. Markus Holzbach
IMD Institut für Materialdesign an der Hochschule für Gestaltung hfg Offenbach am Main
IMD Institute für Materialdesign at the University of art and design hfg Offenbach am Main


Interactive Wood
Die Ästhetik der strukturierten Holzoberfläche wird in der Dunkelheit sichtbar. Die Holzmaserung verbreitet einen schwachen Schimmer, der Licht zur Orientierung bietet. Durch die Berührung mit der Hand wird das Leuchten aktiviert. Nach einer gewissen Zeit schwächt die Beleuchtung ab und die Holzmaserung schimmert noch eine Weile nach.
The aesthetics of the structured wooden surface becomes visible in the dark. The wood grain gives off a faint shimmer that provides light for orientation. The glow is activated by touching it with your hand. After a while, the lighting fades and the wood grain shimmers for a while.
In Kooperation mit / In cooperation with: BMW AG
Projekt von / Project by Johannes Wöhrlin
Projektbetreuung / Supervision: Prof. Dr. Markus Holzbach
IMD Institut für Materialdesign an der Hochschule für Gestaltung hfg Offenbach am Main
IMD Institute für Materialdesign at the University of art and design hfg Offenbach am Main





Perception of Mobility
Das Konzept bewegt sich an der Schnittstelle von Digitalität, analoger Materialität und der intuitiven Geschwindigkeitswahrnehmung des Menschen.
Als analoge Materialbasis dienen Studien mit perforierten Flächen, die je nach Geschwindigkeit den sich ändernden Fahrtwind auffangen und ein holographisches Volumen erzeugen, das zum digitalen transluzenten Projektionsraum wird. Um die menschliche Mobilitätsempfindung aktiv zu beeinflussen, bedarf es sogenannter digital projizierter „motion sequences“. Diese werden mit dem Blickfeld in der Realität überlagert. Es entstehen sogenannte Geschwindigkeitsillusionen.
The concept is situated at the cross section of digitality, analogue materiality and the intuitive perception of speed by humans. Studies with perforated surfaces serve as an analogue material basis, which, depending on the speed, absorb the changing wind and create a holographic volume that becomes a digital, translucent projection space. So-called digitally projected „motion sequences“ are required to actively influence the human perception of mobility. These are overlaid with the field of vision in reality.
In Kooperation mit / In cooperation with: BMW AG
Projekt von / Project by Jan-Simon Maibaum
Projektbetreuung / Supervision: Prof. Dr. Markus Holzbach
IMD Institut für Materialdesign an der Hochschule für Gestaltung hfg Offenbach am Main
IMD Institute für Materialdesign at the University of art and design hfg Offenbach am Main




Organic Interactive Skin
Das automotive Oberflächenkonzept verlagert technische und kommunikative Funktionen in die Fahrzeughaut. Im Zentrum des Konzepts steht das Ziel, Fahrzeuge „lebendiger“ zu machen. Licht agiert auf der gesamten Fahrzeugoberfläche als Kommunikationsmedium.
The automotive surface concept relocates technical and communicative functions to the „skin“ of the vehicle. At the heart of the concept is the goal of making the vehicle “livelier” through Light as a communication medium on the entire surface.
In Kooperation mit / In cooperation with: BMW AG
Projekt von / Project by Frédéric Kreutzer
Projektbetreuung / Supervision: Prof. Dr. Markus Holzbach
IMD Institut für Materialdesign an der Hochschule für Gestaltung hfg Offenbach am Main
IMD Institute für Materialdesign at the University of art and design hfg Offenbach am Main




Transformative Paper
Die Struktur reagiert kontinuierlich auf die einwirkenden Umwelteinflüsse. In Abhängigkeit zur Luftfeuchtigkeit transformiert sich die Papierstruktur in unterschiedliche Zustände. Es entsteht eine Geste, die bei schwacher Feuchtezufuhr so subtil erscheinen kann, dass eine Transformation auf den ersten Blick nicht ersichtlich ist. Bei Einwirkung von Nässe vollzieht sich die Transformation um so intensiver.
The structure reacts continuously to the environmental influences. Depending on the humidity, the paper structure transforms into different states. A gesture is created that can appear so subtle with a weak supply of moisture that a transformation is not apparent at first glance. When exposed to moisture, the transformation takes place all the more intensively.
In Kooperation mit / In cooperation with: BMW AG
Projekt von / Project by Florian Hundt
Projektbetreuung / Supervision: Prof. Dr. Markus Holzbach
IMD Institut für Materialdesign an der Hochschule für Gestaltung hfg Offenbach am Main
IMD Institute für Materialdesign at the University of art and design hfg Offenbach am Main



Transformative Haptics
Das Konzept thematisiert den funktionalen Umgang mit den haptischen Qualitäten eines Materials. Ausgangspunkt ist die menschliche Hand und ihre Bewegungsfähigkeit im dreidimensionalen Raum. Die physische und mentale Handlungsfähigkeit wird erweitert. Die Interaktion findet in der Tiefe des Materials selbst statt und nicht an der Oberfläche. Neuartige Mensch-Objekt-Beziehungen entstehen mit der Konzentration auf das Fühlen und den damit verbundenen hörbaren Auswirkungen.
The concept focuses on the functional handling of the haptic qualities of a material. The starting point is the human hand and its ability to move in three-dimensional space. This physical and mental ability is expanded through the material. The interaction takes place in the depth of the material itself and not on the surface. Novel human-object relationships arise with the concentration on feeling and the associated audible effects.
In Kooperation mit / In cooperation with: BMW AG
Projekt von / Project by Anna-Lena Moeckl
Projektbetreuung / Supervision: Prof. Dr. Markus Holzbach
IMD Institut für Materialdesign an der Hochschule für Gestaltung hfg Offenbach am Main
IMD Institute für Materialdesign at the University of art and design hfg Offenbach am Main


Ceralay
Einsätze aus poröser Filterkeramik regulieren das Raumklima in Abhängigkeit zur Luftfeuchte. Die Filterkeramik ist in dünne Schichten eingepasst, welche als Grenzebene zum Fahrzeuginnenraum dienen. Die Frischluftzufuhr erfolgt über die Umgebungsluft im Außenraum. Die Außenluft steht mit dem Keramiksystem in Verbindung. Die natürliche Art der Klimatisierung kommt ohne Elektrizität aus und nimmt das Funktionsprinzip früherer Lehmbauten auf.
Inserts made of porous filter ceramics regulate the room climate depending on the humidity. The filter ceramic is fitted into thin layers, which serve as a boundary to the vehicle interior. Fresh air is supplied via the ambient air outside. The outside air communicates with the ceramic system. The natural type of air conditioning does not require electricity and takes up the functional principle of earlier clay buildings.
In Kooperation mit / In cooperation with: BMW AG
Projekt von Project by Andreas Hildebrand
Projektbetreuung / Supervision: Prof. Dr. Markus Holzbach
IMD Institut für Materialdesign an der Hochschule für Gestaltung hfg Offenbach am Main
IMD Institute für Materialdesign at the University of art and design hfg Offenbach am Main



F.L.AIR
Die Materialstudie beschäftigt sich mit der gezielten Regulierung von Beleuchtung und Belüftung. Das Material lässt sich durch intuitive Gesten ansteuern. Verschiedene Gesten lösen dabei unterschiedliche Funktionen aus. Inspiration zu dieser Form von Reaktion und Reizausübung bildet die Mimosa Pudica und das Meeresleuchten.
This material study deals with the targeted regulation of lighting and ventilation. Various Functions can be triggered by intuitive gestures. Mimosa Pudica and the glow of the sea are the inspiration for this form of reaction and stimulation.
In Kooperation mit / In cooperation with: BMW AG
Projekt von /Project by Alix Huschka
Projektbetreuung / Supervision: Prof. Dr. Markus Holzbach
IMD Institut für Materialdesign an der Hochschule für Gestaltung hfg Offenbach am Main
IMD Institute für Materialdesign at the University of art and design hfg Offenbach am Main



Voice
Der Wandel zur E-Mobilität eröffnet für die Kommunikationsschnittstelle Mensch-Automobil bisher unbedachte Möglichkeiten. Das Projekt beschäftigt sich mit den kommunikativen Elementen von Motorenlärm und eröffnet neue Möglichkeiten für die Auseinandersetzung mit den Themen Fußgängersicherheit, Lärmbelastung, Kommunikation und Personalisierung. Ein Schwerpunkt der Arbeit liegt in der ästhetischen formgewordenen Darstellung und Wahrnehmung von Geräusch und Lärm.
The transition to e-mobility is opening up previously unthought-of opportunities for the human-car communication interface. The project deals with the communicative elements of engine noise and opens up new possibilities for dealing with the topics of pedestrian safety, noise pollution, communication and personalization. One focus of the work is the aesthetic representation and perception of sound and noise that has become a form.
In Kooperation mit / In cooperation with: BMW AG
Projekt von / Project by Aeneas Stankowski
Projektbetreuung / Supervision: Prof. Dr. Markus Holzbach
IMD Institut für Materialdesign an der Hochschule für Gestaltung hfg Offenbach am Main
IMD Institute für Materialdesign at the University of art and design hfg Offenbach am Main



3D Ceramics
Die im Kurs „3D-Ceramics“ erzeugten Strukturen wurden am 3D-Drucker hinsichtlich ihres Materialeinsatzes und des eingesetzten Produktionsverfahrens optimiert. Der Forschungsaspekt – ohne Unterscheidung von Technologie und Ästhetik – steht im Fokus dieser Arbeiten. Die Form eines Produkts als Ergebnis eines erzeugenden Prozesses.
In Kooperation mit/ In cooperation with: mit Prof. Dr. Wolfgang Kollenberg WZR ceramic solutions GmbH
Projektbetreuung / Supervision: Prof. Dr. Markus Holzbach
IMD Institut für Materialdesign an der Hochschule für Gestaltung hfg Offenbach am Main
IMD Institute für Materialdesign at the University of art and design hfg Offenbach am Main





Soundwaves
Soundwaves ist eine aus Stäben aufgebaute interaktive Struktur, die sich nach akustischen Signalen im Raum ausrichtet. Ähnlich einem Weizenfeld im Wind, werden die akustischen Signale in den harmonischen, wellenartigen Bewegungen der Stäbe sichtbar.
Soundwaves is an interactive structure made up of rods that align with acoustic signals in the room. Similar to a field of wheat in the wind, the acoustic signals become visible in the harmonious, wave-like movements of the sticks.
Projekt von / Project by Timothy Ekins, Steven Kaufmann, Chi Sohns, Marc-Samuel Ulm, Benjamin Würkner
Projektbetreuung / Supervision: Prof. Dr. Markus Holzbach, Dipl. Des. Friedrich Söllner
IMD Institut für Materialdesign an der Hochschule für Gestaltung hfg Offenbach am Main
IMD Institute für Materialdesign at the University of art and design hfg Offenbach am Main




Dynamic Surface
Die symmetrische Struktur des Entwurfs, die in einem kontinuierlichen Übergang zunehmend filigraner wird, verbindet zwei konträre Materialien und deren vollkommen gegensätzliche Materialeigenschaften miteinander. Diese Eigenschaften bilden sich dabei unterschiedlich stark heraus. Die Struktur wird in Bewegung gesetzt und nach verschiedenen Parametern angesteuert.
The symmetrical structure of the design, which becomes more and more filigree in a continuous transition, combines two contrary materials and their completely opposite material properties. These properties develop in different strengths. The structure is set in motion and controlled according to various parameters.
In Kooperation mit / In cooperation with: BASF Designfabrik und Hyundai Motor Deutschland GmbH
Projekt von / Project by Anna-Michèle Hamann
Projektbetreuung / Supervision: Prof. Dr. Markus Holzbach
IMD Institut für Materialdesign an der Hochschule für Gestaltung hfg Offenbach am Main
IMD Institute für Materialdesign at the University of art and design hfg Offenbach am Main


Cutting Tool
Glas und Holz qualifizieren sich durch ihre Eigenschaften für unterschiedliche Einsatzbereiche. Kann ein hybrides Material die Oberflächenhärte von Glas mit der strukturell bedingten Bruchfestigkeit von Holz verbinden? Normales Glas, der Werkstoff von Flaschen oder Fensterscheiben, ist für dieses Experiment ungeeignet: Selbst die sehr heiße Schmelze ist zu zäh, um so filigrane Strukturen wie Holz anzunehmen. Das Ausgangsmaterial wird dabei modifiziert; es entstehen völlig neue Möglichkeiten der Formgebung, Produktion und Anwendung.
Can a hybrid material combine the surface hardness of glass with the structural strength of wood? Glass, the material used for bottles or window panes, is unsuitable for this experiment: even in its hot, molten state it is too tough to imitate the delicate wooden structures. The starting material is modified in the process; completely new possibilities of design, production and application arise.
Projekt von / Project by Markus Mau
Projektbetreuung / Supervision: Prof. Dr. Markus Holzbach
IMD Institut für Materialdesign an der Hochschule für Gestaltung hfg Offenbach am Main
IMD Institute für Materialdesign at the University of art and design hfg Offenbach am Main


Pars pro Toto
Im Entwurfsseminar Integrale Formgenerierung entstanden abstrakte Formen aus UHPC-Beton (Ultra High Performance Concrete). Der Gestaltungsprozess geht dabei einerseits von diesem neuartigen Material aus, andererseits von der seriellen (Re-)Produktion von Objekten im Gießverfahren. Die resultierenden Objekte interpretieren die Eigenschaften der Gussmasse. Er ermöglicht spiegelglatte Oberflächen und Bauteile mit hauchdünnen Wandstärken. In ihren Arbeiten loten die Studierenden die Grenzen dieses Materials aus – mit einem Spektrum von dichten, kompakten Körpern bis hin zu zarten und filigranen Konstruktionen.
In the seminar Integral Form Generation, abstract forms were created from UHPC concrete (Ultra High Performance Concrete). The design process is based on the one hand on this new material and on the other hand on the serial (re)production of objects in the casting process. The resulting objects interpret the properties of the casting compound. It enables mirror-smooth surfaces and components with extremely thin walls. In their work, the students explore the limits of this material – with a spectrum from dense, compact bodies to delicate and filigree constructions.
IMD in Kooperation mit / In cooperation with: G.tecz, Kassel
Projektbetruung / Supervision: Prof. Dr. Markus Holzbach
IMD Institut für Materialdesign an der Hochschule für Gestaltung hfg Offenbach am Main
IMD Institute für Materialdesign at the University of art and design hfg Offenbach am Main






Tactio
Wie beeinflussen Materialien und Strukturen die Wahrnehmung einer Raumsituation, in der die Oberflächen vor allem auf haptische Reize ausgelegt sind? Diese Frage stellt sich zum Beispiel in der gestalterischen Materialuntersuchung für zukünftige Automobilinterieurs.Tactio ist die Materialvision eines „nackten“ Armaturenbretts ohne Bedienelemente, dafür aber mit sensitiven Oberflächenbereichen. Die hochempfindlichen Tastsensoren unserer Fingerspitzen werden durch Mikrostrukturen angeregt. Taktiles Feedback erzeugt eine ungewohnte, aber intensivierte Mensch-Objekt-Interaktion: Einen Gegenstand zu berühren, heißt auch umgekehrt vom Gegenstand berührt zu werden.
How do materials and structures influence the perception of a spatial situation in which the surfaces are primarily designed for haptic stimuli? This question arises, for example, in the material investigation for future automobile interiors. Tactio is the material vision of a „bare“ dashboard without controls, but with sensitive surface areas. The highly sensitive tactile sensors on our fingertips are stimulated by microstructures. Tactile feedback creates an unfamiliar but intensified human-object interaction: Touching an object also means being touched by the object.
In Kooperation mit / In cooperation with: BASF designfabrik und Hyundai Motor Deutschland GmbH
Projekt von / Project by Marlies Kolodziey
Projektbetreuung / Supervision: Prof. Dr. Markus Holzbach
IMD Institut für Materialdesign an der Hochschule für Gestaltung hfg Offenbach am Main
IMD Institute für Materialdesign at the University of art and design hfg Offenbach am Main



Transtextil
Wie erzeugen textile Fertigungsverfahren raumgreifende, dreidimensionale Strukturen und Formen?
Die Polaritäten zwischen der fragilen und zerbrechlichen Anmutung, der Transparenz, der geringen Materialstärke, der hohen Reißfestigkeit, der Stabilität und der Flexibilität des Gefüges verleiht der Fadenkonstruktion faszinierende Gestaltungsspielräume in Anwendungen wie Technik, Medizin oder Architektur.
How do textile manufacturing processes create expansive, three-dimensional structures and shapes? The polarities between the fragile and breakable appearance, the transparency, the low material thickness, the high tear resistance, the stability and the flexibility of the structure give the thread construction fascinating design freedom in applications such as technology, medicine or architecture.
In Kooperation mit / In cooperation with: Prof. Petra Kellner und Dipl.-Des. Bernadette Karl
Projekt von / Project by Marianne Pforte
Projektbetreuung ( Supervision: Prof. Dr. Markus Holzbach
IMD Institut für Materialdesign an der Hochschule für Gestaltung hfg Offenbach am Main
IMD Institute für Materialdesign at the University of art and design hfg Offenbach am Main



Bacterial Composite
Composite sind zusammengesetzte Materialien, welche die Eigenschaften ihrer Bestandteile vorteilhaft miteinander verbinden. Aus dem nachwachsenden Rohstoff Zellulose lassen sich beispielsweise mit Hilfe von genetisch modifizierten Bakterien nanokristalline Fasern produzieren. Im Projekt Bacterial Composite züchteten die Studierenden experimentell Biofilme und kombinierten sie mit natürlichen Textilien, um einzigartige Eigenschaften und Anmutungen für zukünftige Öko-Composite zu erhalten.
Composite materials have the property to advantageously combine the properties of their components. For example, nanocrystalline fibers can be produced from the renewable raw material cellulose with the help of genetically modified bacteria. In the „Bacterial Composite“ project, the students experimentally grew biofilms and combined them with natural textiles to obtain unique properties and appearances for future eco-composites.
In Kooperation mit / In cooperation with: BASF designfabrik und Hyundai Motor Deutschland GmbH
Projekt von / Project by Raffael Costa, Ricardo Ponce
Projektbetreuung / Supervision: Prof. Dr. Markus Holzbach
IMD Institut für Materialdesign an der Hochschule für Gestaltung hfg Offenbach am Main
IMD Institute für Materialdesign at the University of art and design hfg Offenbach am Main



Light Skin
Light Skin ist die Vision einer interaktiven „Haut“ im automotiven Kontext.
Reize wie Berührung, Druck und Vibration werden aufgenommen und als Lichtpunkt wieder ausgegeben: Die Berührung wird sichtbar und gibt ein optisches Feedback.
Light Skin is the vision of an interactive „skin“ in the automotive context. Stimuli such as touch, pressure and vibration are recorded and output as a point of light: the touch becomes visible and provides visual feedback.
In Kooperation mit / In cooperation with: Prof. Peter Eckart, HfG Offenbach, Evonik Industries AG
Projekt von / Project by Martin Pohlmann, Julian Schwarze
Projektbetreuung / Supervision: Prof. Dr. Markus Holzbach
IMD Institut für Materialdesign an der Hochschule für Gestaltung hfg Offenbach am Main
IMD Institute für Materialdesign at the University of art and design hfg Offenbach am Main




Anisotropie
Durch das Zusammenspiel der Anisotropie des Furniers in einer Makrostruktur ist es möglich, abhängig von der Feuchtigkeitsverteilung verschiedene Formen zu generieren. Gesteuert durch die Form und Ausrichtung der Furniermodule werden Strukturen denkbar, die sowohl auf die absolute Feuchtigkeit als auch die Verteilung von Feuchtigkeit im Raum reagieren und durch ihre dreidimensionale Verformung spezifische praktische und ästhetische Funktionen erfüllen.
Through the interplay of the anisotropy of the veneer in a macro structure, it is possible to generate different shapes depending on the moisture distribution. Controlled by the shape and orientation of the veneer modules, structures are conceivable that react to both the absolute humidity and the distribution of humidity in the room and, through their three-dimensional deformation, fulfill specific practical and aesthetic functions.
Projekt von / Project by Florian Hundt
Projektbetreuung / Supervision: Prof. Dr. Markus Holzbach
IMD Institut für Materialdesign an der Hochschule für Gestaltung hfg Offenbach am Main
IMD Institute für Materialdesign at the University of art and design hfg Offenbach am Main


Ceramic Wood
Die Keramiken aus Holz, kurz: Holzkeramik, sind das Ergebnis eines materialinspirierten Prozesses, der sich mit der Frage nach der Komposition konträrer Materialeigenschaften befasst. Kombiniert man die Technologie der Keramikherstellung mit den Eigenschaften von natürlichem Holz, entstehen biomorphe Keramiken. Dieser besondere Werkstoff konserviert den strukturellen Aufbau von Pflanzen in Keramik.
Die Kombination pflanzlicher Strukturen mit keramischen Eigenschaften eröffnet bisher ungenutzte Gestaltungspotenziale. In biomorphen Keramiken können die Ergebnisse natürlicher Evolution zur Verbesserung technischer Systeme genutzt werden.
The ceramics made of wood, in short: wood ceramics, are the result of a material-inspired process that deals with the question of the composition of contrary material properties. If you combine the technology of ceramic production with the properties of natural wood, biomorphic ceramics are created. This special material preserves the structural composition of plants in ceramics. The combination of plant structures with ceramic properties opens up previously unused design potential. In biomorphic ceramics, the results of natural evolution can be used to improve technical systems.
Kooperation mit / In cooperation with: Saint-Gobain Fraunhofer ISC
Gruppenprojekt, Grundstudium
Projektbetreuung / Supervision: Prof. Dr. Jochen Kriegesmann, Prof. Dr. Markus Holzbach
IMD Institut für Materialdesign an der Hochschule für Gestaltung hfg Offenbach am Main
IMD Institute für Materialdesign at the University of art and design hfg Offenbach am Main






Parametric Skin
Parametric Skin ist eine Struktur, die Leder neu erfahrbar macht. Dieses künstliche Strukturbild verändert die natürliche Anmutung des Leders und übersteigert sie, insbesondere beim Übergang von der Fläche in eine dreidimensionale Gestalt. Die digitale Netzstruktur, auf der Parametric Skin beruht, entsteht durch parametrische Programmierung aus der organischen Ledernarbung. So kann sie sich an jede Flächenausprägung anpassen. Das Verzerren der Struktur betont Kanten und bestimmte Bereiche eines Objektes.
Parametric Skin is a structure that allows leather to be experienced in a new way. This artificial structural pattern changes the natural appearance of the leather and exaggerates it, especially in the transition from a flat surface to a three-dimensional shape. The digital network structure on which Parametric Skin is based, is based on an digitalized, organic leather grain. The parametric pattern can adapt to any surface configuration. Distorting texture emphasizes edges and specific areas of an object.
Projekt von / Project by Johannes Wöhrlin
Projektbetreuung / Supervision: Prof. Dr. Markus Holzbach
IMD Institut für Materialdesign an der Hochschule für Gestaltung hfg Offenbach am Main
IMD Institute für Materialdesign at the University of art and design hfg Offenbach am Main



Continua
Im Rahmen des Grundstudiums wurden modulare und variable Raumsysteme entwickelt. Ausgehend von gelenkig verbundenen oder biegesteifen Knotenverbindungen, wurde die Minimalzelle „Knoten“ in einem System von Kontinuitäten oder Diskontinuitäten extrapoliert und daraus unterschiedliche Morphologien generiert. Die material- und systemübergreifenden Systeme werden auf Form-, Kraft- und Materialschlüssigkeit bzw. deren Kombinationen hin entwickelt.
As part of the basic studies, modular and variable room systems were developed. Based on articulated or rigid node connections, the minimal cell „node“ was extrapolated in a system of continuities or discontinuities and different morphologies were generated from this. The cross-material and cross-system systems are developed for positive, non-positive and material locking or their combinations.
In Kooperation mit / In cooperation with Dipl.-Ing. Arch. Tatjana Gorbachewskaja
Projektbetreuung / Supervision: Prof. Dr. Markus Holzbach
IMD Institut für Materialdesign an der Hochschule für Gestaltung hfg Offenbach am Main
IMD Institute für Materialdesign at the University of art and design hfg Offenbach am Main





Phenol
Die Arbeit “Phenol” zeigt, wie sich Flüssigkeiten durch Impulse in ihrer Farbigkeit verändern können. Die Installation “Phenol” interagiert mit dem Pulsschlag des Betrachters. Durch einen Pulssensor, welcher am Körper getragen wird, wird die Herzfrequenz an die Installation übermittelt und so die Färbung des Wassers reguliert. Bei ansteigenden Puls verändert sich die Flüssigkeit von einem leichten Rosa bis hin zu einem intensivem Pink. So entstehen Texturen, die auf direkte Impulse aus ihrer Umwelt reagieren. Die Mensch-Objekt-Interaktion steht im Fokus dieser Arbeit. Die beiden Installationen PHENO und PHENOL werden von Körperzuständen beeinflusst, welche das physische Bewusstsein des einzelnen Individuums hinterfragen.
Die Arbeit wurde auf dem biome symposium in Sidney/AUS präsentiert.
The work „Phenol“ shows how liquids can change their color through impulses. The installation “Phenol” interacts with the viewer’s pulse through a sensor worn on the body. It transmits the heart rate of the spectator to the installation and thus regulates the color of the water. As the pulse increases, the liquid changes from a light pink to an intense pink. This creates textures and patterns that react to direct impulses from their environment. The human-object interaction is the focus of this work. The two installations PHENO and PHENOL are influenced by bodily states that question the physical consciousness of the individual. The work was presented at the biome symposium in Sydney/AUS.
Projekt von / Project by Teresa Mendler
Projektbetreuung / Supervision: Prof. Dr. Markus Holzbach
IMD Institut für Materialdesign an der Hochschule für Gestaltung hfg Offenbach am Main
IMD Institute für Materialdesign at the University of art and design hfg Offenbach am Main



Mucid
Mucid ist eine Sitzlandschaft. Ein Ort für Entspannung, Kommunikation und Meditation. Eine interaktive Sitzgelegenheit, die sich an den Körper anpasst, die reagiert, wärmt, kühlt, je nach Bedarf und Jahreszeit. Die Form ist von der Natur inspiriert. Mucid besitzt die Eigenschaften lebendiger Organismen, und besteht aus einer Kombination von natürlichen und künstlichen Materialien.
Mucid is a seating landscape. A place for relaxation, communication and meditation. An interactive seat that adapts to the body, reacts, warms, cools, depending on the need and the season. Being inspired by nature, Mucid has the properties of living organisms, and is made from a combination of natural and artificial materials.
Projekt von ( Project by Kamile Poliksaite
Projektbetreuung / Supervision: Prof. Dr. Markus Holzbach
IMD Institut für Materialdesign an der Hochschule für Gestaltung hfg Offenbach am Main
IMD Institute für Materialdesign at the University of art and design hfg Offenbach am Main




Keramisches Textil
Diese Materialstudie zeigt, inwiefern bestehende Materialien neu aufgegriffen und kombiniert, oder auch substituiert werden und auf unterschiedlichste Weise in der Gestaltung zum Einsatz kommen können. Die entstanden Objekte stellen keine endgültigen Produkte dar, sondern geben den Anstoß für weitere Interpretationen. Das entwickelte “Keramische Textil” weist einen erstaunlichen Schlankheitsgrad auf. Die fragilen Schalen – mit einem Durchmesser von etwa 30 cm – haben eine Materialstärke von weniger als 1 mm.
This material study shows the extent to which existing materials are taken up and combined in a new way, or substituted and used in a wide variety of ways in the design. The resulting objects do not represent final products, but provide the impetus for further interpretations. The „ceramic textile“ is suprisingly thin. The bowls, with an diameter of approkimately 30 cm, have an material thickness of less than 1 mm.
Projekt von / Project by Thomas Stern
Projektbetreuung / Supervision: Prof. Dr. Markus Holzbach
IMD Institut für Materialdesign an der Hochschule für Gestaltung hfg Offenbach am Main
IMD Institute für Materialdesign at the University of art and design hfg Offenbach am Main



Hybrid
Die Großform des Experimentalbaus “Hybrid” besteht aus einem Möbiuskörper. Dieser fasziniert durch seine scheinbar unendliche Form, da dieser nur eine Fläche und eine Kante besitzt, welche in sich selbst zurücklaufen. Fraktale des Baus wurden im Januar 2011 in der Diamantenbörse in Frankfurt am Main ausgestellt. Die komplexe 3D-Struktur wurde parametrisch generiert und auf Basis eines komplett durchdetailierten CNC-Datensatzes im CNC-Lab gefertigt.
The large form of the experimental building „Hybrid“ consists of a Möbius body, which fascinates with its seemingly infinite form sonce it only consists of one surface and one edge running back into themselves. Fractals of the construction were exhibited in January 2011 at the Diamond Exchange in Frankfurt am Main. The complex 3D structure was generated parametrically and manufactured on the basis of a completely detailed CNC data set in the CNC lab.
Kooperation / Cooperation: Prof. Dr. Patrick Teuffel (TU Delft), Parametric Strategies, Xing Wang, Hyperbody-research group TU Delft, Andreas Schnubel, Rice-Francis–Ritchie RFR – Paris
Teilnehmer_innen / Participants: Vasiliki Corakas, Ayla Ertürk, Annalena Kluge, Steffen Reiter, Marc Ulm, Xiaojia Yao,
Steven Kaufmann, Lilli Lisitchkina, Judith Weber, Julian Staubach
Projektbetreuung / Supervision: Prof. Dr. Markus Holzbach
IMD Institut für Materialdesign an der Hochschule für Gestaltung hfg Offenbach am Main
IMD Institute für Materialdesign at the University of art and design hfg Offenbach am Main




Palina
“… function follows form follows material” – entlang dieser Prozesskette entstand die Leuchte Palina. In ihr sind Übergänge zwischen flüssig, kristallin und fest wie eingefroren. Die in Wechselwirkung gebrachten Materialien nehmen neue Materialien in sich auf, hinterlassen Abdrücke und unerwartete, vielleicht an Korallen erinnernde Reaktionen. Es entsteht eine Materialität der Überraschung und der Übersetzung, der von Palina zu Palina jeweils andere Geschichten eingeschrieben sind.
„… function follows form follows material“ – the Palina light was created along this process chain. The Object seems to befrozen in the transitions between liquid, crystalline and solid. The interacting materials absorb new materials, leaving coral-like imprints and unexpected reactions. A materiality of surprise and translation emerges, in which different stories are inscribed from Palina to Palina.
Projekt von/ Project by Annalena Kluge, Elena Bollin
Projektbetreuung / Supervision: Prof. Dr. Markus Holzbach
IMD Institut für Materialdesign an der Hochschule für Gestaltung hfg Offenbach am Main
IMD Institute für Materialdesign at the University of art and design hfg Offenbach am Main





